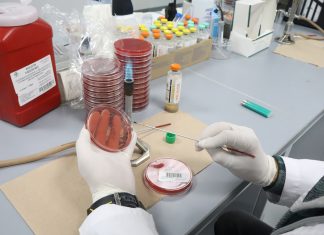

Las mujeres son más propensas a la destrucción del pensamiento
La construcción del pensamiento es un proceso que inicia desde el nacimiento y depende tanto de aspectos biológicos como ambientales. Una formación escolar limitada,...
Microbioma y baños saludables en un bosque amenazado
La UdeG impulsa una terapéutica que conecta con la naturaleza a través de los cinco sentidos, combinando salud holística, microbiomas y el valor ancestral...
Expertos de UdeG proponen mesa técnica sobre calidad del agua
Ante los problemas en la calidad del agua turbia, maloliente, con algas y microorganismos, especialistas en agua de la Universidad de Guadalajara (UdeG) proponen la instalación...
Hospitales Civiles de Guadalajara aparecen en el ranking World’s Best Hospitals...
El ranking World’s Best Hospitals, realizado por Newsweek y Statista, reconoció en su edición 2026 las unidades hospitalarias del Hospital Civil de Guadalajara (HCG), lo...
Hemocultivos optimizan tratamientos en pacientes del HCG
Hemocultivos optimizan tratamientos en pacientes del HCG
Desde el Laboratorio de Microbiología se trabaja en detectar infecciones en cultivos de sangre de quienes entras al Servicio...
Del gis al algoritmo: enseñar en tiempos de inteligencia artificial
opinión
GACETA/ ACADEMIA/ INVESTIGACIÓN / CONOCIMIENTO
En un inicio, el conocimiento no se mostraba terminado en el pizarrón, se iba construyendo paso a paso. Hoy la...
Inteligencia artificial: retos, oportunidades y transformación educativa
Inteligencia artificial: retos, oportunidades y transformación educativa
El debate sobre esta nueva tecnología ya abarca todos los sectores, no solo profesionales, sino de la vida...
Niñas migrantes en México, un fenómeno invisibilizado
Desde hace algunas décadas los flujos migratorios comenzaron a cambiar su composición: ya no se trataba sólo de varones adultos que viajaban rumbo al...
Therians ¿moda o tendencia?
opinión
GACETA/ ACADEMIA/ INVESTIGACIÓN / CONOCIMIENTO
Therians ¿moda o tendencia?
En la actualidad este fenómeno alcanzó una visibilidad mediática global, sobre todo con la ayuda de las...
Cómo influyen la relaciones sociales en la salud mental y emocional
Los estados emocionales están está íntimamente vinculados a la interacción que se tiene con otras personas y al contexto en el que se desarrollan, señaló...